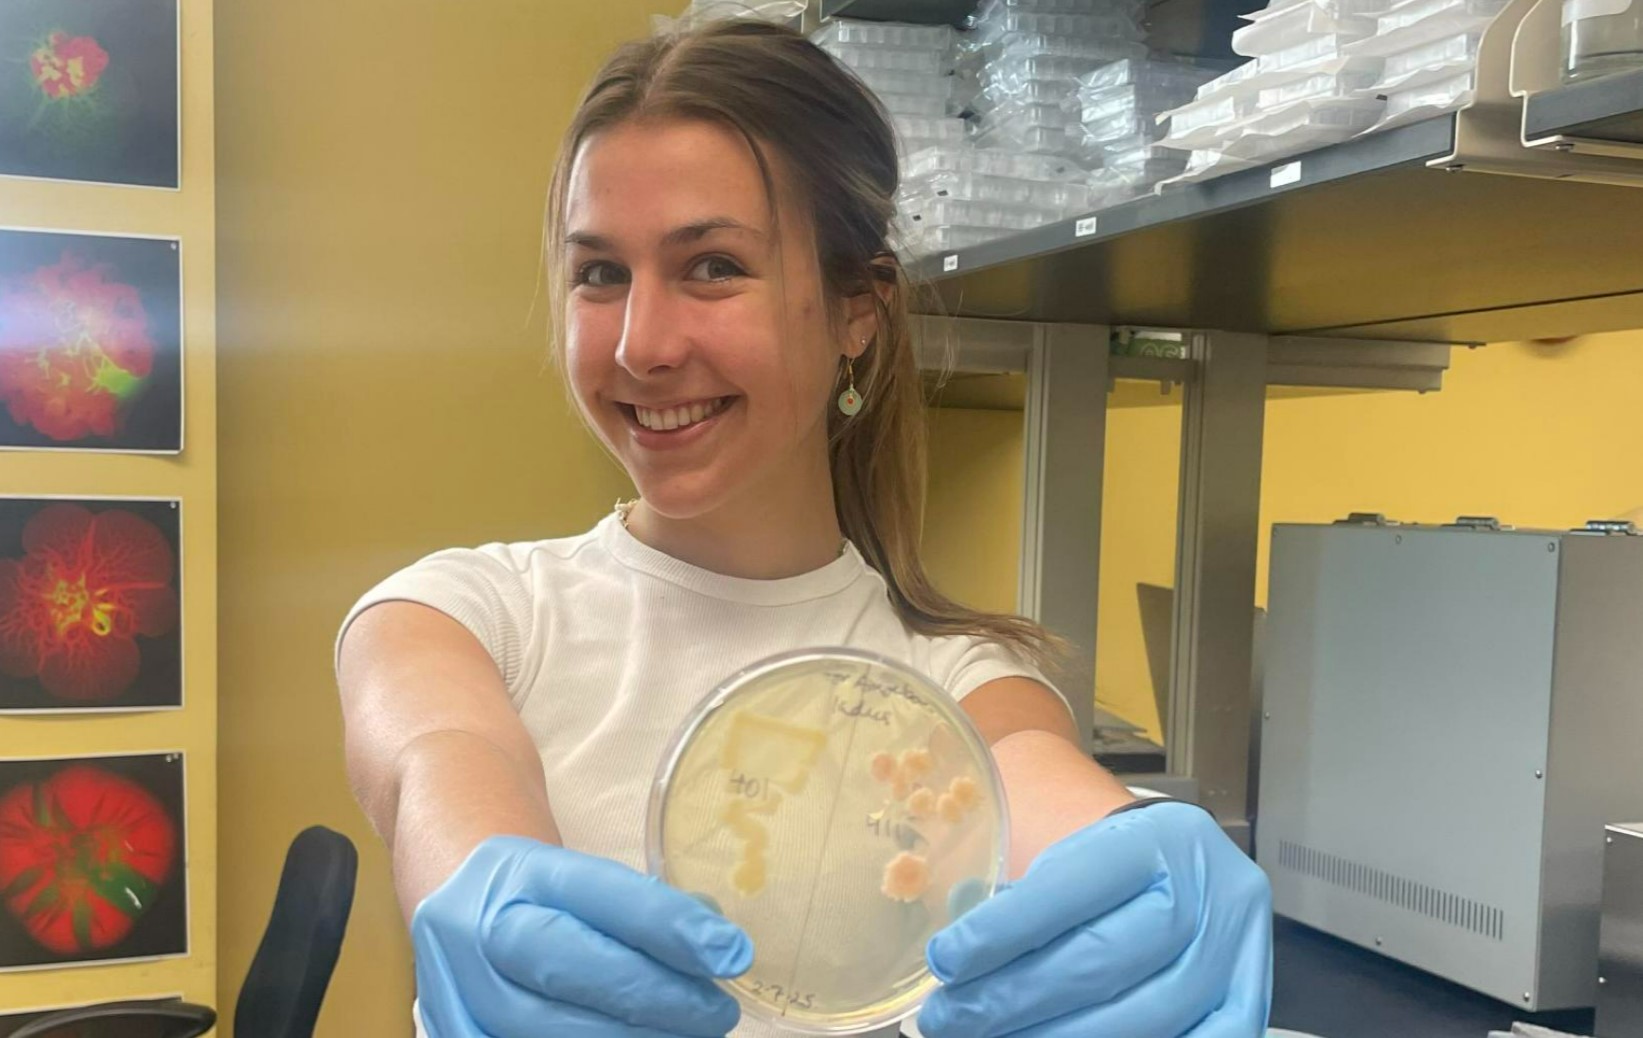
macie-mcgraw-26

A Legacy That Keeps Giving
The late Charlotte Mangum’s enduring influence as a biology professor at William & Mary continues to reach new students through an endowment created by a group of devoted alumni. In addition to the prestigious Charlotte Preston Mangum Prize for graduating seniors and the annual Mangum Lecture, the endowment now supports fellowships for student research.
Since 1998, 32 graduating seniors have been recognized with the Mangum Prize for outstanding research in the field of biology. Originally $500, the award has increased to $1,000 in recent years, and recipients’ names are each inscribed on a cast bronze statue of a blue crab that is housed outside the third-floor offices in Integrated Science Center (ISC) 3. In 2023, the Charlotte Preston Mangum Biology Endowment provided funds to establish the annual Mangum Lecture. This year’s event takes place on Friday, April 4, featuring Christopher Lowe, a biology professor at Stanford University’s School of Humanities and Sciences. Professor Lowe is an expert on the evolution of development in marine invertebrate animals. The talk is open to the W&M community and will be held at 4 p.m. in ISC Room 1221.

“These students represent the best of William & Mary: academic excellence combined with a dedication and drive to push the boundaries of our knowledge through research,” says Jonathan Allen, an associate professor of biology. “We are so grateful that Charlotte’s former students had the foresight and willingness to support our current students and build her legacy through the Mangum Endowment.”
Charlotte Mangum, who passed away in 1998, taught at William & Mary for over 30 years, beginning in 1964. According to a tribute written by former students Lou Burnett ’73 and Peter deFur ’72, M.A. ’77, P ’96, “More than 70 undergraduate and graduate students came out of Charlotte’s lab with a clearer understanding of the practice of science and much more.”
A group of alumni initially created a fund in Mangum’s honor in 1998, and two decades later they led an effort to ensure its continuation. Then, in 2022, they established the endowment to maintain the Mangum Prize and expand on it, first with the lecture and now the research fellowship, to make the professor’s legacy and impact even more visible and lasting.
One of the former students dedicated to honoring Mangum’s memory is Lynn Amende ’72, who helped spearhead efforts to create the Mangum Endowment along with Lou Burnett ’73 and Karen Gray Burnett ’72, Malcolm Shick '69, M.A. ’71 and Jean Michael Shick ’68, among others.
Amende, who lives in Florida, retired after a career as a scientific review administrator at the National Institutes of Health, including positions at the National Cancer Institute, the National Institute of Nursing Research and the National Heart, Lung, and Blood Institute. She credits Mangum’s encouragement, mentorship and professional connections for placing herself and others in key internships that helped propel their careers. For Amende, one of those experiences was in the Chesapeake Biological Laboratory in Solomons, Maryland.
“The internship enabled me to see what research was like outside of an academic setting, so I could see the kinds of job opportunities I would have with a Bachelor of Science degree, a master’s or a Ph.D.,” she says. “Before the end of the summer, I said, ‘I'm going to get my doctorate.’”
Amende recalls that Mangum also would arrange for her students to present their research at the Virginia Academy of Science, providing them with vital career preparation.
“She drove the van with four or five of us up to Richmond and she made certain we had a place to stay,” Amende says. “She went above and beyond the normal expectations for mentoring.”
Mangum also taught a summer course in invertebrate zoology for several years at the Marine Biological Laboratory in Woods Hole, Massachusetts, providing an opportunity for W&M biology students to accompany her and study tuition-free.
When Amende applied to graduate schools, Mangum again was instrumental in helping her make connections, leading her to the University of Maryland, where she received master’s and doctoral degrees in zoology.
Malcolm Shick ’69, M.A. ’71, a professor emeritus of zoology and oceanography at the University of Maine’s School of Marine Sciences, recalls that an invertebrate biology course he took with Mangum as a sophomore captured his interest.
“She delved into the historical, intellectual and scientific underpinnings of what she was teaching, so it was almost like a history of biology course,” he says, adding that the class required an independent research project culminating in a scientific paper.
“She gave us a precise guide for authors: Here is what goes into a scientific paper and what doesn’t, and how to structure the paper,” he says. “It was my first hint of what lay beneath the surface of marine biology and working in science.”
Current Mangum Fellow Grace Hussey is a research assistant in W&M’s Developmental Biology Lab, working with Chancellor Professor Margaret Saha to investigate embryonic nervous system development in the African clawed frog (Xenopus laevis).
“Conducting biological research under the legacy of professor Mangum and other William & Mary scientists has been the pinnacle of my undergraduate years,” Hussey says. “With the support of the Mangum Fellows program and guidance from my mentors, I have had the opportunity to explore my academic interests and make contributions to the scientific community. I hope to continue professor Mangum’s spirit of intellectual curiosity, mentorship and passion in my current and future endeavors.”
Rebecca Zheleznyak says she plans to use her Mangum Fellows program funds for her honors thesis as well as to contribute to the William & Mary iGEM tea
m (iGEM stands for international Genetically Engineered Machine.)
“I am truly grateful to receive the Magnum fellowship, not only because of the wonderful message that it represents, but also because of the opportunities it grants students,” she says. “The fellowship allows students to pursue their passions in biology research, and I am honored to be one of those lucky students.”
As more students like Hussey, Zheleznyak and the other Mangum Fellows gain inspiration and knowledge through awards and lectures in Charlotte Mangum’s name, the beloved professor’s legacy will live on at William & Mary and beyond. Likewise, students who have been touched by Mangum's legacy will continue to make an impact as scholars, scientists and educators.